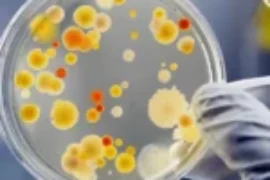
الأمراض الناجمة عدوى البكتيريا الحلزونية في القطط

تبرز القطط اللارادي هو عدم القدرة على الاحتفاظ بالبراز، مما يؤدي إلى الإخراج غير الإرادي للمواد البرازية. رغم أن تبرز القطط اللارادي قد يحدث في أي عمر للقطط لكن أحتمال حدوثه يزداد مع تقدم القطط بالعمر. اعراض تبرز القطط اللارادي اسباب تبرز القطط اللارادي تزداد الحالة سوءاً مع امراض أو جراحة الشرج والمستقيم أو إذا كان […]
كورابيتس الاحدث مقالات
ما يجب عمله عند ارتفاع حرارة القطط وضربة الشمس

ارتفاع حرارة القطط وضربة الشمس يمكن أن تكون قاتلة إذا لم يتم التعامل معها بسرعة وفعالية. يجب العلم أن تعرض القط لنوبة واحدة من ارتفاع درجة الحرارة أو ضربة الشمس يزيد من احتمالية حدوث نوبات أخرى بسبب الضرر الذي يلحق بمركز تنظيم درجة حرارة الجسم في الدماغ. ارتفاع حرارة القطط هو ارتفاع في درجة حرارة الجسم […]
الأمراض التي تسبب إنتان القطط وعلاجه

إنتان القطط استجابة عامة (نظامية) للعدوى البكتيرية (مثل الحمى أو انخفاض ضغط الدم المعروف باسم “انخفاض الضغط”). اعراض إنتان القطط اسباب إنتان القطط البكتيريا، عوامل المرض غالبًا ما تكون بكتيريا سالبة الجرام أو اللاهوائية الإجبارية، السالمونيلا هي أكثر البكتيريا سالبة الجرام شيوعًا التي تتم زراعتها. تم عزل بكتريا البسويدوموناس عند زراعة دم بعض الحيوانات المصابة […]
المرض المسبب لفقدان البروتين في الجهاز المعوي للقطط

المرض المسبب لفقدان البروتين (PLE) هو أي مرض يتميز بفقدان مفرط للبروتينات من الجسم إلى الجهاز الهضمي (المعدة، الأمعاء الدقيقة، والأمعاء الغليظة). الأمراض المرتبطة بفقدان البروتين تشمل أمراض الجهاز الهضمي الأولية واضطرابات عامة (جهازية) مثل أمراض الجهاز الليمفاوي، أو فشل القلب الاحتقاني (حالة لا يستطيع فيها القلب ضخ كمية كافية من الدم لتلبية احتياجات الجسم) […]
اسباب ارتفاع الكالسيوم في دم القطط ومعالجته

ارتفاع الكالسيوم في دم القطط يعني المستويات الزائدة أو المرتفعة من الكالسيوم في بلازما دم القطط (اكثر من 10.5 ملغ/ديسيلتر). سببه الاساسي فرط نشاط الغدة جارات الدرقية الأولي وبشكل خاص في سلالات القطط السيامية. فرط نشاط الغدة جارات الدرقية الأولي يشير إلى حالة يكون فيها ورم في الغدة جارات الدرقية ينتج كميات زائدة من هرمون […]
اعراض تسمم القطط بالأسيتامينوفين وعلاجه

على الأسيتامينوفين لقططهم، وهو دواء يُستخدم للتحكم في الألم أو الحمى لدى البشر. أيضاً هناك نقص وراثي لبعض السلالات في تحويل أو تكسير بعض الأدوية في الكبد. مما يجعل هذها القطط عرضة لسمية الأسيتامينوفين. القطط الصغيرة والصغيرة الحجم بالأخص معرضة بشكل أكبر للتسمم الناجم عن جرعة واحدة من الأسيتامينوفين التي يقدمها المالك لها. اعراض تسمم […]
الأعراض الناجمة عن فطر الكوكسيديوسس عند القطط

تُعد العدوى الفطرية عند القطط من الحالات الصحية التي قد تتسبب بقلق كبير لدى المربين، خاصة إذا كانت نادرة أو معقدة مثل فطر الكوكسيديوسس عند القطط. هذا المرض الفطري الخطير، الذي قد ينتقل عبر استنشاق أبواغ فطرية دقيقة من التربة، يمكن أن يؤدي إلى أعراض تنفسية وعصبية خطيرة في القطط. في هذا المقال الشامل، نستعرض […]
تقرحات فم القطط والتهاب الأنسجة حول اسنان القطط المزمنة

تعتبر صحة الفم جزءًا أساسيًا من الرعاية اليومية للقطط. إلا أن الكثير من المربين قد يواجهون مشكلات صعبة مثل تقرحات فم القطط، والتي يمكن أن تكون مؤلمة للغاية وتؤثر على شهية القطة وسلوكها العام. في هذا المقال، سنستعرض كل ما تحتاج معرفته عن هذه الحالة: من الأسباب والأعراض إلى طرق العلاج والوقاية، بلغة مبسطة تناسب […]
اسباب صعوبة بلع الطعام عند القطط وكيفية التعامل معه

هل لاحظت أن قطتك تعاني من صعوبة في بلع الطعام؟ ربما تكون قد رصدت بعض التغيرات في سلوكها أثناء الأكل، مثل محاولاتها المتكررة للبلع أو وضع رأسها بشكل غير طبيعي. هذه العلامات قد تشير إلى مشكلة صحية تحتاج إلى اهتمام فوري. في هذا المقال، سنستكشف بالتفصيل كل ما يتعلق بصعوبة بلع الطعام عند القطط ، […]
الأمراض الناجمة عدوى البكتيريا الحلزونية في القطط
ة، قرحة المعدة، وسرطان المعدة غيّر جذريًا فهمنا لأمراض المعدة لدى البشر. هذا الاكتشاف سلط الضوء أيضًا على أهمية فحص تأثير هذه البكتيريا على الحيوانات الأليفة مثل القطط والكلاب. أنواع الهيلوباكتر في القطط أنواع من الهيلوباكتر تم عزلها من معدات القطط تشمل: حتى الآن، لم يتم العثور على الهيلوباكتر بايلوري في القطط إلا في مستعمرة […]

